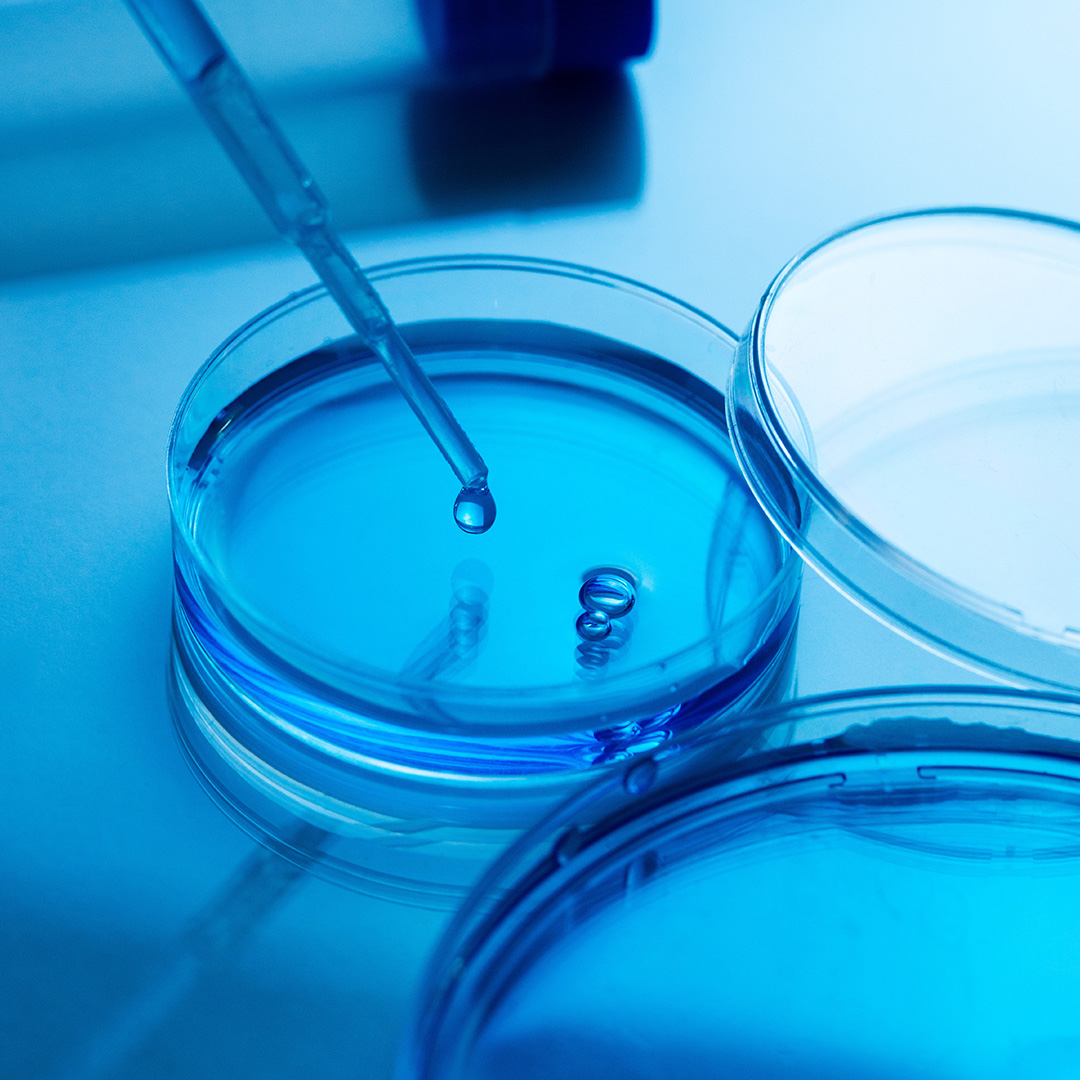

Kompleksowe podejście.
Realne efekty.

PORTFOLIO
/
Medycyna
KLIENT
Bacteromic
BRANŻA
Medycyna
REALIZACJA
2024
USŁUGI
Produkt fizyczny
Konstrukcja
Prototypowanie
ZAKRES
projekt wzorniczy, konstrukcja, CMF
BACTEROMIC to innowacyjny system diagnostyczny stworzony z myślą o szybkim i skutecznym testowaniu wrażliwości bakterii na antybiotyki (AST - Antimicrobial Susceptibility Testing).
Celem projektu było opracowanie urządzeń, które połączą w sobie funkcjonalność i ergonomię użytkowania z wysokimi wymaganiami technicznymi, mechanicznymi i produkcyjnymi. Kluczowe było stworzenie prostych, nowoczesnych i spójnych wizualnie form, które jednocześnie odpowiadają na potrzeby użytkowników w codziennej pracy laboratoryjnej.

W projekcie poszukiwano sposobu kształtowania formy, łączącego prostotę z charakterystycznym wyrazem spójnym z wizerunkiem marki. Podstawą koncepcji stał się układ oparty na siatce, pozwalający na uzyskanie sekwencji pionów i poziomów. W efekcie powstały dwie komplementarne bryły urządzeń - analizator i napełniarka. Projekt wzorniczy został dostosowany do technologii cięcia, gięcia blach giętych i termoformowania.




Na dalszym etapie projektu zespół opracował serię mock-upów z materiałów zastępczych, co pozwoliło na przeprowadzenie testów użytkowych i opracowanie ostatecznej, w pełni funkcjonalnej formy produktu gotowego do wdrożenia.


Źródło: materiały marketingowe Bacteromic
Poznaj nasz HUB
Każde zgłoszenie analizujemy indywidualnie. Wkrótce skontaktuje się z Tobą odpowiednia osoba z naszego zespołu, aby porozmawiać o Twoim pomyśle i możliwych kierunkach jego realizacji.”
Potrzebujesz dobrego projektu?
Skontaktuj się z nami.
Każde zgłoszenie analizujemy indywidualnie. Wkrótce skontaktuje się z Tobą odpowiednia osoba z naszego zespołu, aby porozmawiać o Twoim pomyśle i możliwych kierunkach jego realizacji.”
Dziękujemy za wiadomość!
Zajmiemy się nią jak najszybciej i wrócimy z odpowiedzią w ciągu 24 godzin.
Wyślij ponownieOdwiedź nas
ul. Przemysłowa 13
30-701 Kraków, Polska
Copyright 2025 Ergo Design - Projektowanie i design produktu
Ergo Design Sp. z o.o.
REGON 356581930





